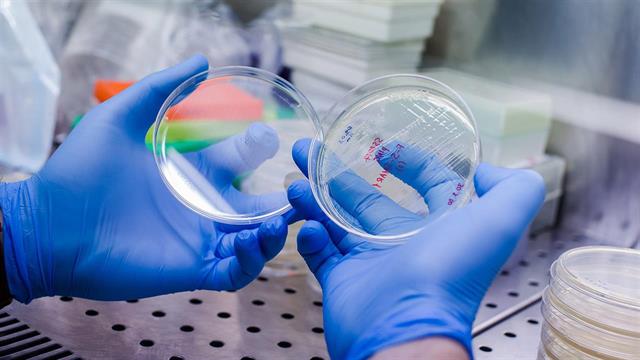
Πρώτη δοκιμή ανοσοθεραπείας με in-house παραγόμενα 3ης γενεάς CAR-T λεμφοκύτταρα

Την έγκριση της υποβολής αίτησης χρηματοδότησης του ερευνητικού έργου με τον υπό διαμόρφωση τίτλο: «In house παραγωγή 3ης γενεάς, γενετικά τροποποιημένων με χιμαιρικούς αντιγονικούς υποδοχείς Τ λεμφοκυττάρων (CAR T) ως θεραπεία Β-αιματολογικών κακοηθειών» στην Ειδική Υπηρεσία Διαχείρισης και Εφαρμογής Δράσεων (ΕΥΔΕ) στους τομείς της Έρευνας και Καινοτομίας στο Πρόγραμμα «Ανταγωνιστικότητα» ΕΣΠΑ 2021-2027 «ΕΡΕΥΝΩ – ΚΑΙΝΟΤΟΜΩ», αποφάσισε το Γενικό Νοσοκομείο Θεσσαλονίκης Γ. Παπανικολάου.
Πρόκειται για την πρώτη στην Ελλάδα κλινική δοκιμή υιοθετούμενης ανοσοθεραπείας με in-house παραγόμενα 3ης γενεάς, CAR-T λεμφοκύτταρα που αναμένεται να οδηγήσει στη διευρυμένη και οικονομικά συμφέρουσα εφαρμογή της σε ασθενείς με Β λεμφώματα.
Στόχος της προτεινόμενης σύμπραξης θα είναι η “in house”, GMP-παραγωγή και χορήγηση καλά χαρακτηρισμένων, 3ης γενεάς CAR-T λεμφοκυττάρων, ειδικών έναντι του αντιγόνου CD19, για την αντιμετώπιση Β Λεμφώματος από Μεγάλα Λεμφοκύτταρα (BCL).
Η επαναστατική ανοσοθεραπεία με γενετικά τροποποιημένα με χιμαιρικούς αντιγονικούς υποδοχείς Τ λεμφοκύτταρα (CAR T λεμφοκύτταρα), είναι σήμερα σημαντικό εργαλείο στη θεραπευτική φαρέτρα των αιματολόγων, καθώς δίνει νέες δυνατότητες θεραπείας σε εκείνους τους ασθενείς με αιματολογικές κακοήθειες που μέχρι σήμερα, είχαν πολύ περιορισμένες επιλογές και εξαιρετικά χαμηλό προσδόκιμο επιβίωσης. Η θεραπευτική αυτή στρατηγική, αξιοποιεί το ανοσοποιητικό σύστημα του ίδιου του ασθενούς, προσδίδοντάς του ιδιότητες αναγνώρισης και επίθεσης στα καρκινικά κύτταρα.
Στην προσέγγιση αυτή, τα Τ λεμφοκύτταρα συλλέγονται από το περιφερικό αίμα ασθενούς (ή υγιούς δότη) μέσω λευκαφαίρεσης, τροποποιούνται γενετικά στο εργαστήριο - ώστε να μπορούν να αναγνωρίσουν ένα αντιγόνο-στόχο που εκφράζεται στα λευχαιμικά/καρκινικά κύτταρα και να τα εξαλείψουν πολλαπλασιάζονται, ψύχονται, και σε δεύτερο χρόνο εγχύονται στον ασθενή. Μετά την έγχυσή τους, τα CAR T λεμφοκύτταρα παραμένουν στην κυκλοφορία του ασθενή και αναγνωρίζουν τα κακοήθη κύτταρα, ως ένα «ζωντανό φάρμακο», πολλαπλασιάζονται και επιτίθενται στα καρκινικά κύτταρα, επιφέροντας σε υψηλά ποσοστά ύφεση ή ακόμη και ίαση, σε πρωτοπαθώς ανθεκτικές ή σε υποτροπή Βκακοήθειες.
Μέχρι σήμερα 5 σκευάσματα CAR T λεμφοκυττάρων 2ης γενεάς, μεγάλων φαρμακευτικών εταιρειών έχουν λάβει έγκριση από τον Ευρωπαϊκό Οργανισμό Φαρμάκων (ΕΜΑ). Σε όλες τις περιπτώσεις τα κύτταρα του ασθενούς συλλέγονται στο κέντρο θεραπείας του, μεταφέρονται στο διαπιστευμένο εργαστήριο των φαρμακευτικών εταιρειών, όπου παράγονται τα CAR T λεμφοκύτταρα, και το τελικό κυτταρικό προϊόν επιστρέφει στο κέντρο νοσηλείας του ασθενούς για να γίνει η χορήγησή του. Η συνολική διαδικασία παραγωγής είναι χρονοβόρα (έως 45ημέρες) και το τελικό CAR-T προϊόν ιδιαίτερα κοστοβόρο, καθώς αποζημιώνεται περίπου στις 350.000-400.000 ευρώ/ ασθενή.
Το νοσοκομείο Παπανικολάου είναι διαπιστευμένο για τη θεραπεία με CAR Τ λεμφοκύτταρα και η ΜΓΚΘ αδειοδοτημένη από τον Εθνικό Οργανισμό Φαρμάκων για την παραγωγή προϊόντων προηγμένων θεραπειών.
Οι Φορείς που θα συμμετάσχουν στο προτεινόμενο έργο, όπως έχει διαμορφωθεί έως σήμερα, είναι οι ακόλουθοι:
- Συντονιστής φορέας: Γ.Ν.Θ. Γ.Παπανικολάου: Μονάδα Γονιδιακής και Κυτταρικής Θεραπείας (ΜΓΚΘ)–Αιματολογική-Μονάδα Μεταμόσχευσης Αιμοποιητικών Κυττάρων (ΜΜΑΚ).
- HeCOG: H Ελληνική Συνεργαζόμενη Ογκολογική Ομάδα (EΣΟΟ) ή Hellenic Coοperative Oncology Group (HeCOG), μια μη-κερδοσκοπική Επιστημονική Εταιρεία Παθολόγων-Ογκολόγων.
- Δημοκρίτειο Πανεπιστήμιο Θράκης: Τμήμα Μοριακής Βιολογίας και Γενετικής, Σχολή Επιστημών Υγείας.
- ΑΝΤΙΣΕΛ: ΑΝΤΙΣΕΛ Αφοι Α. Σελίδη ΑΕ, εταιρεία επιστημονικών προϊόντων και τεχνολογιών.
- ΦΑΡΜΑΣΙΣΤ: ΦΑΡΜΑΣΙΣΤ Μονοπρόσωπη Ε.Π.Ε., οργανισμός έρευνας συμβάσεωνμ(CRO) κλινικών μελετών.
- AGILIS: AGILIS AE, Εταιρεία στατιστικής και πληροφορικής ανάλυσης μελετών.
Οι αντικειμενικοί στόχοι της παρούσας ερευνητικής πρότασης είναι:
Α) η προκλινική ανάπτυξη και επικύρωση παραγωγής σε GMP συνθήκες 3ης γενεάς CAR-Τ κυτταρικών προϊόντων (ΜΓΚΘ).
Β) η διερεύνηση της αποτελεσματικότητας αυτών των CAR-T σε ζωικό μοντέλο λεμφώματος (ΜΓΚΘ).
Γ) η, για πρώτη φορά στην Ελλάδα, κλινική μελέτη χορήγησης in house παραχθέντων 3ης γενεάς CAR-T λεμφοκυττάρων για Β-λεμφώματα (ΜΓΚΘ-ΜΜΑΚ, Φαρμασιστ/Agilis)
Δ) η διερεύνηση συσχέτισης γενωμικών ή/και μεταγραφικών χαρακτηριστικών των CAR-T κυτταρικών προϊόντων ή του μικροπεριβάλλοντος της νόσου i) με τη σχετιζόμενη με την CAR-T θεραπεία τοξικότητα και ii) με την απόκριση στη θεραπεία (HECOG)
Ε) η διερεύνηση του ρόλου του μικροβιώματος στην τοξικότητα ή αποτελεσματικότητα της CAR-Tsανοσοθεραπείας (Δημοκρίτειο)
ΣΤ) η ανάπτυξη νέων προγνωστικών κιτ ως εργαλεία προσδιορισμού του κινδύνου ανάπτυξης σοβαρής τοξικότητας ή της απάντησης στην CAR-T θεραπεία (Αντι-σελ)
Ζ) Ανάλυση σχέσης κόστους/απόδοσης (cost-effectiveness study) της in-house παραγωγής CAR-T θεραπείας σε σχέση με τα εμπορικά διαθέσιμα προϊόντα(Φαρμασιστ/Agilis).
Προσθέστε το iatronet.gr στο Discover
Ειδήσεις υγείας σήμερα
Μπορούν τρόφιμα να ενισχύσουν την απορρόφηση της βιταμίνης D;
Ημέρα του Πατέρα: Διατροφικές επιλογές για καλύτερη υγεία
Πρωινές συνήθειες που βοηθούν στη δυσκοιλιότητα
Eυρώπη: Η πρόσβαση στις θεραπείες CAR-T παραμένει ασυνεπής
Eυρώπη: Η πρόσβαση στις θεραπείες CAR-T παραμένει ασυνεπής Ολοκληρώνεται το "σπίτι" των κυτταρικών και γονιδιακών θεραπειών - Πότε θα λειτουργήσει
Ολοκληρώνεται το "σπίτι" των κυτταρικών και γονιδιακών θεραπειών - Πότε θα λειτουργήσει 'Eτοιμο σε 4 μήνες
'Eτοιμο σε 4 μήνες Τα υπάρχοντα συστήματα αποζημίωσης δεν ευνοούν τις κυτταρικές και γονιδιακές θεραπείες
Τα υπάρχοντα συστήματα αποζημίωσης δεν ευνοούν τις κυτταρικές και γονιδιακές θεραπείες Healthcare Transformation - Αντ. Καρόκης: Η πρόκληση των γονιδιακών και κυτταρικών θεραπειών [βίντεο]
Healthcare Transformation - Αντ. Καρόκης: Η πρόκληση των γονιδιακών και κυτταρικών θεραπειών [βίντεο] siREN: Χρυσό μετάλλιο στη θεραπευτική πρόταση του ΑΠΘ για τη χρόνια λεμφοκυτταρική λευχαιμία
siREN: Χρυσό μετάλλιο στη θεραπευτική πρόταση του ΑΠΘ για τη χρόνια λεμφοκυτταρική λευχαιμία Μπορούν τρόφιμα να ενισχύσουν την απορρόφηση της βιταμίνης D;
Μπορούν τρόφιμα να ενισχύσουν την απορρόφηση της βιταμίνης D; Ημέρα του Πατέρα: Διατροφικές επιλογές για καλύτερη υγεία
Ημέρα του Πατέρα: Διατροφικές επιλογές για καλύτερη υγεία Πρωινές συνήθειες που βοηθούν στη δυσκοιλιότητα
Πρωινές συνήθειες που βοηθούν στη δυσκοιλιότητα Βρώμη και κινόα: Πώς συγκρίνονται από άποψη πρωτεΐνης
Βρώμη και κινόα: Πώς συγκρίνονται από άποψη πρωτεΐνης Ρύζι, πατάτες και ζυμαρικά: Ποιο είναι χειρότερο για το σάκχαρο;
Ρύζι, πατάτες και ζυμαρικά: Ποιο είναι χειρότερο για το σάκχαρο; Με ποιες τροφές να συνδυάζω ρύζι, πατάτες και ζυμαρικά για να μην αυξάνεται απότομα το σάκχαρο
Με ποιες τροφές να συνδυάζω ρύζι, πατάτες και ζυμαρικά για να μην αυξάνεται απότομα το σάκχαρο Pharmathen: Βαθιά κρίση και μηδενισμός αποτίμησης από funds της Partners
Pharmathen: Βαθιά κρίση και μηδενισμός αποτίμησης από funds της Partners Καρπούζι: Ποια είναι τα οφέλη του στην υγεία
Καρπούζι: Ποια είναι τα οφέλη του στην υγεία Ισχυρή πρωτιά της ΔΗΚΙ στις εκλογές του Ιατρικού Συλλόγου Αθηνών - Ρεκόρ συμμετοχής
Ισχυρή πρωτιά της ΔΗΚΙ στις εκλογές του Ιατρικού Συλλόγου Αθηνών - Ρεκόρ συμμετοχής Ιατρικός Σύλλογος Θεσσαλονίκης: Σαρωτική επικράτηση της ΕΝΟ.ΣΥ. - Ν.Ι.Κ.Ι.
Ιατρικός Σύλλογος Θεσσαλονίκης: Σαρωτική επικράτηση της ΕΝΟ.ΣΥ. - Ν.Ι.Κ.Ι. Φαρμακοβιομηχανίες σκέφτονται να χτυπήσουν την πόρτα της Εθνικής Αρχής Διαφάνειας
Φαρμακοβιομηχανίες σκέφτονται να χτυπήσουν την πόρτα της Εθνικής Αρχής Διαφάνειας Οι απρόσμενες συνέπειες της ολοκληρωτικής παράλειψης της ζάχαρης από τη διατροφή [μελέτη]
Οι απρόσμενες συνέπειες της ολοκληρωτικής παράλειψης της ζάχαρης από τη διατροφή [μελέτη]